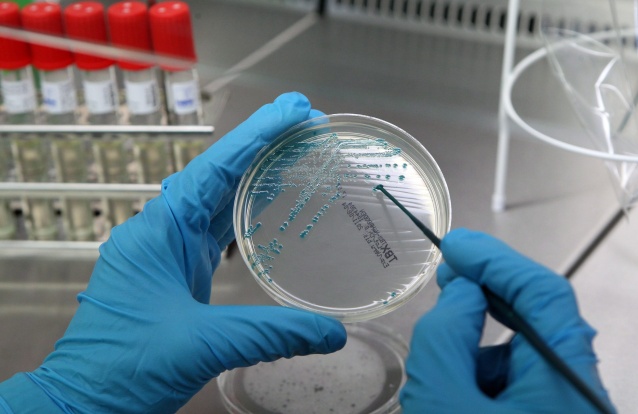

Em 1752, arqueólogos encontraram vários papiros enrolados numa villa pertencente ao sogro de Júlio César na cidade de Herculaneum, vizinha de Pompeia e que sofreu o mesmo destino depois da erupção do Vesúvio. Ao tentar desenrolá-los, rapidamente se aperceberam que estes se desintegravam facilmente, pelo que se decidiu mantê-los enrolados, com os textos a ficarem ocultos até agora. Um Investigador da Universidade de Nebraska-Lincoln usou um programa de aprendizagem de máquina para conseguir decifrar a palavra ‘roxo’ em grego antigo naqueles documentos.
O trabalho de Luke Farritor foi realizado no âmbito do concurso Vesuvius Challenge, que tem mais de um milhão de dólares em dinheiro para quem use Inteligência Artificial, aprendizagem de máquina e visão de computador para identificar letras e palavras nestes rolos. Por ter sido o primeiro a decifrar uma palavra, Farritor ganhou 40 mil dólares. Outros dois cientistas ganharam dez mil dólares cada um: o primeiro por ter decifrado, por outros meios, a mesma palavra que Farritor e o segundo por ter desenvolvido as técnicas que levaram à descoberta.
Entre os líderes desta iniciativa estão Nat Friedman e Daniel Gross, investidores em tecnologia, e Brent Seales, que desenvolve técnicas de imagem e de aprendizagem de máquina há 20 anos para decifrar estes papiros. “Parabéns ao estudante de ciências de computador de 21 anos que é a primeira pessoa a ler estes manuscritos em quase 2000 anos (…) Isto é o sonho de muitas pessoas desde que os papiros foram descobertos nos anos 1750”, afirma Nat Friedman, citado pela Vice.

A expetativa é que estes documentos revelem mais sobre o estilo de vida e feitos conseguidos na antiguidade.
Os investigadores vão agora concorrer para o grande prémio de 700 mil dólares que irá para quem consiga descodificar quatro passagens, cada uma com 140 caracteres de texto seguidos. O prazo termina às 23h59 de 31 de dezembro deste ano.